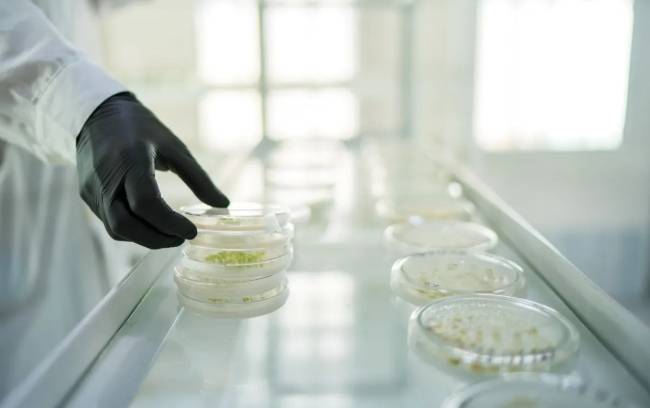

Los cambios en las reglas de auditoría de laboratorios extranjeros para la inspección de semillas de plantas agrícolas por parte de la Agencia de Supervisión de Semillas de Plantas Agrícolas de Rusia entrarán en vigor el 1 de septiembre de 2025. Según los materiales de la agencia, las inspecciones ya no requerirán la aprobación de las autoridades extranjeras competentes.
La agencia informó: “En particular, se eliminó la obligación de coordinar con autoridades extranjeras autorizadas las auditorías realizadas por funcionarios de la Agencia de Inspección de Semillas de Plantas Agrícolas de Rusia a sus laboratorios para confirmar la capacidad, los métodos y los resultados de las investigaciones”.
La nueva base para realizar auditorías consiste en cualquier tipo de documento: una solicitud de auditoría y la información sobre la eliminación de irregularidades identificadas en auditorías previas. Los laboratorios extranjeros o las autoridades autorizadas de su país envían los documentos al servicio ruso, y la notificación de auditoría se envía al laboratorio extranjero.
Estas reformas también afectan las regulaciones federales sobre la supervisión de la calidad y seguridad de los granos y los productos derivados de su procesamiento. Esta regulación se complementó con una norma que estipula que la Agencia de Supervisión Agrícola y de Seguridad Alimentaria de Rusia (Rosselkhoznadzor) supervisa federalmente los granos durante su cultivo. Anteriormente, Rusia no tenía una regulación explícita al respecto.
También se modificó la lista de información que debe incluirse en el Sistema Federal de Información Geográfica (FGIS) “Granos” para el registro y mantenimiento de entidades legales y empresarios dedicados al almacenamiento de granos y la prestación de servicios de almacenamiento. La lista de servicios ahora incluye servicios de procesamiento de granos.